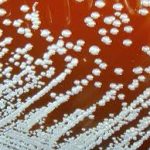

Danyan
活久见!沈腾扮王菲与那英同台
沈腾在模仿腾格尔之后又玩性大发,他在综艺节目中梳起双丸子发型、打上大腮红模仿王菲,却被指撞脸米老鼠,那英更是被逗得频频笑场。
再度唱起《相约98》,比起以往的青涩,现在舞台上的那英更显沉稳,舞台上女王气势十足。只是曾经一旁对唱的王菲却变成了沈腾,顶着丸子头,穿着粉红西装的沈腾力图还原当年的王菲,只是丸子头造型的沈腾被网友指出还是更像米老鼠。录制期间,因为沈腾的造型太过搞笑导致那英笑场,舞台上一向淡定的那英用实力诠释“没眼看”,当场连问工作人员“这谁给他化成这样了”。
虽然沈腾的模仿虽然造型上似乎更像米老鼠,但是对王菲神态的模仿还得到了那英的认证,称沈腾演出了王菲不屑一顾的感觉只是隐隐凸起的青筋显示那英面对沈腾版“王菲”憋笑也是很怒力了。
在歌曲最后,那英与沈腾也重现了当年的合唱画面牵手致谢,网友们纷纷表示“敬佩那英能忍笑和沈腾唱到最后!”还有网友笑话沈腾的造型“腾哥是想哪吒闹海吗?”
张嘉倪又被喷了!这次是因为…
近来频频被批“情商低”的张嘉倪可以说是遇到了新的麻烦。由于现在的明星都喜欢在网上分享自己的护肤心得,张嘉倪也不例外,她分享的就是自己的“美白”心得。就是这样一件小事,让她又遭受到了很多人的群嘲。
那就是视频中的她明显脸和脖子都不是一个颜色的,还来推荐美白产品,这让很多观众不得不产生了很大的质疑。
除此之外,就是还有很多人扒出了张嘉倪的生图,并不是像电视中那么岁月静好,反而非常黑,尤其是脸和身上,形成了非常大的反差。
很多网友就在她的视频下面评论,“也不看看自己什么样,还来推荐美白产品”。
黄金地段酒店拖欠租金4年 高达1.5亿!
地知名五星级酒店上海世纪皇冠假日酒店(简称“假日酒店”)被爆陷入租赁合同纠纷!假日酒店所在的金隆大厦,业主为341名爱尔兰人,爱尔兰业主方近日向本报爆料,这家入住率常年居高不下的酒店,已近4年未付租金,拖欠金额高达1.5亿余元(人民币,下同),经过漫长的法律诉讼无果,“发生这样的事简直令人难以置信。”
“假日酒店几年没有付租金,却仍可以营业赚钱,这非常非常奇怪,在爱尔兰绝对不会发生这样的事情,”金隆大厦被指为涉及爱尔兰公民最多的一笔在华投资,爱尔兰业主方人员Sammy对本报记者表示,近4年的漫长上诉令业主们难以接受,“大家感到沮丧、气愤和绝望。”
位于浦东民生路的金隆大厦,实际投资者为341名爱尔兰人。2006年,温州一家公司与金隆大厦产权人签订期限为13年、月租金300万元的租赁合同,并将承租的楼层用于酒店经营,即假日酒店。爱尔兰业主方表示,承租方从2013年10月后出现系列违约行为,先是租金支付逾期,之后就拒绝提交银行履约保函,2015年2月开始更未再支付租金。为尽快解决欠租问题,爱尔兰业主方已向上海市外办、商委、公安局等部门反映情况。
“澎湃新闻”2015年曾报道称,假日酒店一度因租金纠纷,被断水断电导致停业,但承租方否认拖欠租金。爱尔兰业主方提供的资料显示,2015年,法院一审判决认定合同解除日期为同年12月16日,承租方应结清租金并支付逾期付款违约金。但案件今年2月被二审法院以程序不当为由裁定发回重审,原因是341名产权人当中,有1人在一审判决之前死亡。
美国最新研究:套个耳环就可以避孕?
很多人都会因避孕的问题而烦恼。最近美国佐治亚理工学院的化学家发明了一种最新的避孕方式——避孕耳环。只要将一个一平方厘米大小的贴片贴在耳环上佩戴,就可以实现避孕的目的。
这个小小的白色贴片其实含有合成激素,而这些激素可透过佩戴者耳垂的皮肤进入血液中,完成阻止精子与卵子结合的任务,避免女性意外怀孕。最令人惊喜的是,发明它的科学家说:如果正确使用这个耳环,几乎可以完美避孕。
科学家称,这种技术未来也有希望应用于手表、戒指、项链等配饰。这种避孕药贴最初是为一些欠发达国家人群设计的,因为这些国家的女性获得保健和科学避孕的机会比较有限。
很重要!心脏骤停 急救三步走!
近日,一名中年男子在北京市东单体育馆锻炼过程中突然倒地,恰好有六名北京协和医院的医生在旁边打羽毛球,因而及时赶到。经初步判断,该男子为心脏骤停,情况紧急。六名医生当机立断,迅速分工:呼叫120,同时立即跪在旁边,轮流进行胸部按压;随后取来自动体外除颤仪(AED)进行抢救。四次电击除颤加上医生们不停的心肺复苏,十几分钟后,患者终于转为自主心律,赶到的救护车将病人迅速转到附近的北京同仁医院急诊。经过继续积极救治,半个多小时后病人苏醒过来,并能讲话。整个救治过程彰显了医生的医者仁心,更是为心脏骤停的院外急救提供了范本。
北京协和医院急诊科主任医师朱华栋告诉记者,当发现有人倒地时,首先应评估现场的环境是否安全,在排除了环境危险的情况下鉴别患者情况:1.拍打肩部并大声呼喊患者,看有无反应;2.判断有无自主呼吸:跪下来平视患者胸腹部,观察5~10秒看有无规律起伏,当发现无反应和无自主呼吸,即可初步判断为心脏骤停,应立即拨打急救电话,并开始进行急救。
心脏好比一个“泵”,会把血液泵到全身,当心脏骤停时,“泵”就会停止工作,导致身体各器官缺血。大脑细胞失去供血4~6分钟就会坏死,失去供血8分钟就可能会出现“脑死亡”,导致神经系统难以恢复,抢救心搏骤停者有“黄金四分钟”的说法。因而如果心脏骤停1分钟内,可以获得高质量心肺复苏,抢救成功率能达90%以上。每延误1分钟,抢救成功率就会下降10%。以此类推,当超过10分钟后,才开始进行心肺复苏,则抢救成功率非常低。
对于非专业施救人员来说,当现场只有一个施救者时,如果可以立即取得自动体外除颤器(AED),应首选AED,如果无法立即取得,应马上做人工心肺复苏。当现场有两个及以上施救者,可一人先做心肺复苏,让另一人尽快取得并使用AED。北京协和医院急诊科主治医师王江山介绍说,AED是一种可以自动分析特定的心律失常,能通过电击除颤抢救心源性猝死患者的医疗设备。AED操作十分简单。打开电源,根据语音提示按步骤操作即可。按照仪器上的图示贴好电极片,把插头插入插座。此时仪器会自动分析患者心律,判断身体情况。如果判断患者不需要除颤/电击,AED就不会充电工作;如果语音提示需要除颤/电击,施救人就可按下除颤/电击按钮。使用AED电击除颤时施救者和周边人不应触碰患者身体,其他时刻应尽可能持续进行人工心肺复苏。
王江山详细介绍了人工心肺复苏的方法,人工心肺复苏要做到两点,一是胸外按压(如图1),二是人工呼吸。胸外按压是为了手动“泵”血,把血挤压到全身各脏器。实施胸外按压过程中,要让患者仰卧在硬平面上,保持呼吸道畅通,将掌根放在胸部中央胸骨中下部(定位方法:两个乳头连线中点),双掌根重叠,十指相扣,肘关节伸直,垂直向下按压30次,成人速率至少100次/分,不超过120次/分,按压深度至少5厘米,不超过6厘米。每次按压确保胸廓完全回弹,放松时,救助者的掌根不离开伤员胸部,但不能用力倚靠在胸部,按压和放松的时间相等。
人工呼吸时,施救者要捏住患者鼻孔,包严嘴,向患者缓慢吹气,时间为一秒钟。吹气时眼睛同时斜视胸廓,见胸部明显隆起即可,2次吹气后再进行胸外心脏按压。一组胸部按压和人工呼吸的比例是30:2,也就是说持续按压30次,进行2次人工呼吸;之后再循环操作下一组,直到患者恢复自主循环。
在整个抢救过程中,应尽可能保证胸外按压不间断,或尽可能缩短按压中断的时间(如进行人工呼吸时、更换按压人员时、使用AED时等)。心肺复苏与AED的早期有效配合使用,是抢救心跳呼吸骤停病人最有效的手段。其中AED不仅使用简单,还能大大提高心源性猝死患者抢救成功的几率,因此我国正在加强公共场所自动体外除颤仪的配置和其使用。
爱吃莲藕?挑选的时候记住这三不要
挑莲藕,很多人喜欢选又白又嫩的。殊不知,这样的莲藕可能是被亚硫酸溶液泡过的。大家千万不要被藕的外表迷惑,选择时有“三不要”。
第一,闻气味,散发淡淡酸味的藕不能要。好的藕带有泥沙,胖胖大大,外皮粗糙,凑近了闻一闻,能闻到泥土的腥气。被亚硫酸溶液泡过的藕外表白净,摸起来滑滑的,却散发着淡淡的酸味。
第二,看颜色,过水就变黑的不要。藕放的时间一长就会变色,但被亚硫酸泡过的藕就算放上很多天也依然白净如新。但是,只要一过水,被泡过的藕就会迅速变质,一开始是发黄,再后来是变黑。
第三,尝味道,生吃味酸的不要。藕的种类不同,有的藕生吃是苦的,有的藕生吃是甜的。如果生吃是酸的,说明这个藕很可能被亚硫酸或是其他酸性溶液泡过。
健身人群 别忘记补充这个
随着健身风潮越来越盛,很多人会有意识地吃蛋白质粉来增肌。但对健身者而言,更需要的可能是维生素B族。
维生素B族是维持神经兴奋度和保持精力充沛的重要物质,它能加快能量代谢,消耗堆积脂肪,提高锻炼效果,助长肌肉力量。运动时补充的蛋白质和碳水化合物,需要大量维生素B族帮助代谢,如果消耗过多导致其缺乏,可能引起代谢障碍、免疫力下降甚至致病。维生素B族由12种以上组成,其中跟运动密切相关的是维生素B1、维生素B2以及维生素B6。
维生素B1主要跟碳水化合物代谢相关,还会影响脂肪代谢。运动量越大,消耗量越高。维生素B1的主要食物来源是粗粮、牛奶、蛋黄、瘦肉、植物种子。
维生素B2与脂肪、碳水化合物、蛋白质的代谢都有关,缺乏时易出现各种炎症,包括口角炎、唇炎等。维生素B2的主要食物来源是动物肝脏、蛋黄、牛奶、豆类、绿叶蔬菜。
维生素B6与蛋白质的代谢相关,体内的糖原转变为可利用的葡萄糖、氨基酸转变为能量都需要维生素B6。维生素B6的主要食物来源是动物肝脏、瘦肉、豆类、全谷物。
建议健身者多吃富含维生素B族的食物,如果运动量非常大,可适当服用补剂,但最好找专业人员评估后再补充。
首艘国产航母涂装 阅兵或承担要角
随着解放军海军节的临近,中国首艘国产航空母舰的动向牵动人心。自三月下旬以来,国产航空母舰甲板开始摊铺新涂层,半个月时间完工面积近总量一半,目前施工进展顺利。
据香港《文汇报》报道,在大连造船厂附近观察发现,大批工人放弃节假日休息,仍在航空母舰上加班作业,甲板呈现已完工的灰黑、涂完底漆的锈黄和尚未摊铺的浅灰共三种颜色。
国产航空母舰此前于2月27日离开码头,开始进行第五次试航,3月4日返回大连造船厂。从此次试航的周期看,试航时间相当短,可能没有进行说明复杂的测试。
国产航空母舰飞行甲板上没有出现舰载机着舰或者触舰复飞的黑色轮胎印,显示该舰并未进行舰载固定翼飞机起降试验。
4月23日是中国海军建军70周年纪念日,中国军方已决定举行多国海军活动,包括国际舰队检阅。有猜测称,国产航空母舰可能将加入到国际舰队检阅,与辽宁舰一道组成中国首个双航空母舰编队供中共军委主席习近平检阅。
高云翔被起诉后首发声 维护妻子董璇
高云翔就“高云翔董璇正式被起诉”一事发声。高云翔在微博中表示,电视剧《巴清传》投资方唐德影视起诉的是自己,与妻子董璇无关。此外,高云翔就自己近年来“性侵风波”向大众致歉。
近日,电视剧《巴清传》投资方唐德影视对高云翔和董璇的公司提起诉讼。在已公布的法院档中,这起“演出合同纠纷”案已被受理,预计于7月19日公开审理。此条消息一出,“高云翔董璇正式被起诉”一词登上热搜。4日下午,高云翔在个人微博对此事发声称“所有事皆因我而起,唐德起诉的是我高云翔,被告人中没有董璇”。此外,高云翔表示自己一直在积极配合处理,不希望“亲人和无辜的人再受到牵连”。
目前高云翔仍被要求留在澳洲接受相关调查。此次也是高云翔自性侵风波后首度公开发声,高云翔在微博中表示自己非常非常抱歉,“给大家添了很多麻烦”。至于此前一直没有发声的原因,高云翔则称是为了“不占用更多的公共资源”。
微博也开启了半年可见功能?她已经开始用了!
热门网络社交平台微博上线了“近半年内博文可见”的新功能,一时间引发了众人的热切讨论,不过就在该功能上线两小时后,有细心的网友发现,作为该平台用户的赵丽颖已经开始悄悄使用了。
3月8日刚刚诞下孩子的赵丽颖,现在还是处在坐月子的期间,之前更博十分频繁的她,几乎每天都要在社交平台上发布新消息。但在生了孩子之后,至今只更新过两条动态。其中一条还是为了宣传电视剧。
就在大家以为赵丽颖为了做好月子,保证有个好身体迎接工作,而在网络上销声匿迹时,她的这个紧跟潮流隐藏之前博文的小举动,却暴露了自己时刻都在关注新鲜事物的事实。
可就是这样一个新的尝试,却引起了不少网友的猜测,甚至有网友直言道这么快就用上这个功能,难道是因为心虚,想隐藏自己从前发过的黑历史。
不过网友会有这样的质疑,很大程度上,是源于2018年10月,赵丽颖和冯绍峰“官宣”结婚之后,疯狂删除自己之前发布过的博文的举动。
邓紫棋开演唱会要吸氧 人生第一次
G.E.M.(邓紫棋)与经理人虽然发生合约纠纷尚未解决,不过她仍继续专心忙于巡回演唱会,但被封为“小巨肺”的她,最近到马来西亚云顶开骚时要吸氧气。
原来云顶处于高达海拔2,000米,G.E.M.在表演期间既要跳舞又要唱歌,必定花费不少体力应付,所以开骚前要吸氧气补充,由于演唱会中途出现头晕,于是需要再补充吸氧气以免体力不支。
G.E.M.于社交平台上载一张在后台吸氧气的相片,她留言说:“人生第一次,吸氧气开演唱会⋯⋯真难忘!Needed some oxygen!Lol. Unforgettable!”
章子怡自曝为汪峰拼命 怀孕五个月在雨里奔跑
章子怡常驻的旅行综艺开启墨尔本之旅。在去餐厅的路上,一行人偶遇了在街头唱歌的华人,唱到汪峰的歌曲《无处安放》时,章子怡还回忆起当初帮汪峰拍这个MV时,自己怀孕五个多月仍在雨中奔跑。
节目中,妻子团在去餐厅的路上偶遇了一位在街头唱歌的华人,最后作为结束曲,大家还一起唱了汪峰写给子怡的那首《无处安放》。“没有你我那颗叮叮当当的心啊,总是这样,这样无处安放”,在熟悉的旋律下,子怡回忆起当初自己为这首歌拍摄MV时发生的一些事。透露说拍这个时自己已经怀孕五个多月了,因为剧情需要自己淋雨奔跑,所以即使怀着孕也照做了,还调侃到这都是为了他。另一边,棚内的汪峰也开启炫妻模式,直夸子怡感情到位,演绎的很好。
敷着面膜去洗头 她也是拼了!
沈梦辰在微博发出两张自拍照,照片中她敷著厚厚的泥状面膜,在理发店里吹头发,笑言道:“每次这样来洗头身边的人都会露出惊恐的眼神,似看非看的瞄我几眼。”语气十分调皮。
微博发出后,粉丝纷纷在评论区留言说道:“确实惊恐,理发师真的没下手打你吗姐?”“后面的tony老师怎么还没吓跑。”“太炸眼了姐,洗发店最靓的姐无疑了。”
昨天安省师生大游行 到底去了多少人?!
成千上万名教师及学生,周六在女皇公园(Queen's Park)安省议会大楼外举行示威,抗议省府削减教育开支,裁减教师职位。安省教育厅长周五称,省府的教育政策,不会被工会发起的示威活动影响。 示威活动由5个教师工会发起,大批家长、学生及教育局委员参与。约170部巴士从全省各地区将教师带到示威活动现场。根据现场保安人员估计,约有1万人参与。
在基秦拿(Kitchener)一所中学教戏剧,以及英语作为第二语言课程(ESL)的史密斯(Kristen Smyth)指出,省府要增加班级人数,令学生无法得到应有的关顾,特别是ESL学生,因为他们需要更多的个人辅导。 许多自选科目被取消 省府在三月时宣布,将中学班级的平均人数,从22人增加到28人,并将小学四至八年级的平均班级人数,增加1人至24.5人。此外,省府亦计划在未来四年内,削减至少3,475个全职教师职位,以节省8.51亿元的开支,省府称会透过“自然流失”方式削减。但有工会领袖指,部分支援员工已被裁。
有教育局成员警告称,省府的削支计划,可能导致班级人数达到40人,并导致许多自选科目被取消,一些自闭症支援项目也会遭到削减。在上周四,来自600间学校,超过10万名学生参加罢课行动,抗议省府的教育政策。省长福特指称,工会领袖是该次罢课行动的幕后黑手。在基秦拿一所中学任教的怀特(Marissa White)称,她教的班级现有33名学生,如果省府再增加班级人数,课室根本容纳不下。她不明白为何有人会认为,削减教育经费对孩子有好处。
在密西沙加(Mississauga)一所中学担任辅导员的纽霍克(Ross Newhook)表示,省府削减教育开支,学生将更难获得一些重要的支援服务,例如精神健康的支援项目。他又指出,学生的精神健康问题现在越来越严重,如果再增加班级人数,将令教师无法处理有精神问题的学生。纽霍克将于明年退休,他参加示威,是因为他为安省的学生感到忧虑,他最关注的是学生和教育质素问题。 省府无意修改其教育改革计划 省府的教育改革计划,虽然遭到教育工作者及学生的强烈反对,但安省进步保守党政府依然表示,无意修改其教育改革计划。
教育厅长汤普森(Lisa Thompson)周五发表声明,指省府的政策不会受到工会发动的示威活动影响,安省教师工会在过去15年,一直操控本省的教育系统,现在是进行改革的时候。 汤普森又称,无论工会成员口里说什么,他们最关心的并不是学生的成绩。学生的数学分数不断下降,学生的成绩亦越来越跟不上。 根据安省教育厅发表的资料,学生的5年中学毕业率,由2004年的70%上升至2017年的86.3%。中学生2017年的数学成绩,与2006年比较没有分别,但小学生的数学成绩却有所下降。
小心!有人冒充警察进你家训练警犬
咸美顿警方表示,收到报案指一名冒充警察警犬队的男子,向霍普山(Mount Hope)地区的居民讹称,由于要“训练警犬”,需要进入房屋。
警方表示,一名男子在上周四上午10时走到位于Homestead Drive夹Strathearne Place的一所房屋,要求屋主借出房屋,作为训练警犬之用。
该名男子当时穿着类似警服的深色衣服,并驾驶一辆没有警队标示的深色汽车。
警方称,屋主当时同意该男子进入屋内,并离开了住所。
后来有人报警,但当警方在附近地区搜索时,并没有找到该男子。
警吁民众查问警员编号
另一名邻居向警方表示,一名男子在同一段时间,向屋主作出类似要求。屋主当时相信该男子是执法人员,于是让他使用房屋。
警方指,该名男子并非警员,也不属于任何执法机构。
警方呼吁当地居民检视保安摄录机,查看是否拍到疑犯。
该名疑犯被形容为白人男子,年约35至45岁,短金发,胡须刮得很干净。
警方称,如果民众对警员身分有怀疑,应该要求提供警员编号,并打电话向警方确认。如果该人拒绝提供警员编号,民众应该记下该人的面貌和车牌号码,并立即报警。
警方呼吁知情者致电905-546-8963,与探员克鲁什曼(Jeff Clushman)联络。
房东因装修下逐客令后 收到信用警告
一家多伦多信用咨询公司发出警告。最近多伦多频频出现装修驱逐现象,也就是说,由于租金价格不断上涨,房东称需要对公寓单位进行装修后再出租,要求租客搬出。
CBC报道,破产信托公司Hoyes Michalos经理Scott Terrio说,过去3个月间,他就接待了6名财务陷入困境的客户。 他们都是被房东驱逐的租客,因为房东计划重新装修单位。根据房东租客法专家的说法,“装修”是一个合法的驱逐理由。但是在昂贵的多伦多租赁市场,如果想要重新找地方住,你需要拿得出第一个月和最后一个月房租的按金。这笔钱金额不少,Terrio说,一些被驱逐的租户发现他们被逼到了破产的边缘。 他说:“他们中有些人不得不找发薪日借款公司(payday lender)去借钱,或者寻求分期付款的贷款,这些借款或者贷款当然有很高的利息。”
“一旦你这样做,你财务上就很难翻身了。” 这种境遇Paul Kolinski很熟悉。他在the College与Dovercourt交界地区一栋可负担低层公寓楼的一套单身公寓里住了10年。他的房东坚称需要装修整栋楼,强行要求他搬走。 音乐人被逼迁陷困境 Kolinski是一名音乐人,他每月为这套单身公寓支付830元房租外加上水电费。他不愿意搬走。 他说,搬到一个新的、更贵的地方,会带来财务困难。“租赁市场价格猛涨,我的收入可没有跟着升。我不相信我能在大多区任何地方找到类似我现在住的公寓。”
安省租赁住宅提供者联盟(the Federation of Rental Housing Providers of Ontario)总裁Tony Irwin说,从法律上说,房东装修后,必须允许被驱逐的租户搬回来,房租必须和原来相同。 房东还必须出示所在城市发出的建筑许可证,证明确实是要进行大规模装修,而“不是刷层油漆那么简单”。 同时,如果租户居住在一栋有5个及以上单位的楼里,若他们由于装修被迫搬走,他们有资格要求获得相当于3个月房租的赔偿。 Irwin说:“对租客们有强有力的保护措施,我们联盟的成员们都是遵守法规的,认为租客应受到尊重。” 但是城市租户协会联盟(the...
这些标注“健康产品”的中成药 被联邦卫生部禁了!
联邦卫生部在亚省卡加利的中药店检获一些声称为健康产品,包括壮阳药丸、感冒丸和皮肤药膏等药物。由于该批药物未获本国许可出售,可能会对健康构成危险,当局已下令停售,并呼吁公众切勿使用。
卫生部在卡城的Sunrise Lee Chinese Herbs Centre中药店(999 36th Street NE),检获未经许可出售的“健康产品”,成分属于处方或被禁止售卖的药物,大部分包装印上中文字。有关产品的成分、使用量及副作用,消费者未能明白。
当局指出,处方药通常用于治疗某类疾病,可能引起严重的副作用,必须在医护人员指导下才可以使用。未经本国授权出售的药物,在安全、效用及质素等方面存疑,可能带来严重的健康风险。
未批准药物含严重风险
该批未经授权的药物未经卫生部批准,这意味着未经过安全性、有效性和质量评估,可能造成严重的健康风险。另外,这些药品可能含有标签上未列出的成分或添加剂,可能缺乏有效成分,或者可能与其他药物和食品产生相互作用。由于上述原因,在加拿大销售这些未经授权的健康产品是非法的。
今次被卫生部禁止出售的成药产品,分别是:
(1)白云山感冒药(Compound Diclofenac Sodium and Chlorphenamine Maleate Tablets);
(2)复方醋酸地塞米松乳膏(Dexamethasone Acetate Cream);
(3)醋酸氟轻松乳膏(Fluocinonide Cream);
(4)醋酸氟轻松乳膏(Fluocinonide Cream 0.025%);
(5)一轻松通便片(I-Ching-Sung Diacetyldiphenolisatin 5mg Tablets);
(6)Yansuan Jinmeisu Yangao(盐酸金霉素眼膏);
(7)Yohimbe...
新致命神秘病菌全球扩散:紧急威胁!
近年发现的一种多重抗药性的神秘致命病菌耳念珠菌(Candida auris),被曝正在全球扩散,据悉,目前在欧洲、亚洲、北美洲、南美洲及非洲的医疗机构造成感染,美国纽约州、新泽西州及伊利诺州迄今录得587宗感染耳念珠菌个案,美国疾病控制及预防中心(CDC)已将之列入“紧急威胁”病菌名单。
据《纽约时报》报道,去年5月,一名90岁长者在纽约市布鲁克林区西奈山医院接受腹部手术,验血时发现他感染了最新发现的致命病菌耳念珠菌。医生马上将他转往深切治疗部隔离。该名长者入院90天后死亡,医疗人员发现他入住的病房内布满耳念珠菌。西奈山医院院长洛林表示,该病房的墙壁、病床、房门、窗帘和电话等,都验出布满耳念珠菌。由于这种病菌攻击性强,院方使用特别清洁器具清理病房,并将病房的部分天花板和地板拆除,以清除耳念珠菌。 耳念珠菌为近年兴起的念珠致病菌株,具有多重抗药之特性,攻击免疫系统衰弱的病人。
与大多数其他念珠菌属不同,该菌种会在医疗机构内传播,可能对全球公卫及医疗造成威胁,引起业界相当大的关注。耳念珠菌已在欧洲、亚洲、北美洲、南美洲及非洲的医疗机构造成感染,英国一间医疗中心感染耳念珠菌后,关闭深切治疗部以根除这种病菌,耳念珠菌也传到印度、巴基斯坦、南非。 耳念珠菌对主要抗菌药物都具有抗药性,是全球上升的抗药性感染最新例子。 耳念珠菌引起的征状是平常的发烧、肌肉痛及疲倦,但感染者特别是已带病的人,会因这些征状而致命。美国疾控中心表示,接近一半感染耳念珠菌的病人,会在90天内死亡。
耳念珠菌最近传入纽约州、新泽西州及伊利诺州,疾控中心已将耳念珠菌列入“紧急威胁”病菌名单。 耳念珠菌在2009年最先在日本病人的外耳道验出,但国际专家仍未能确定它最早在哪里出现。美国迄今录得587宗耳念珠菌感染个案,其中纽约州有109宗,新泽西州有104宗,康涅狄格州有144宗。 美国最早发现耳念珠菌个案是在2013年5月6日,一名来自阿联酋的61岁女子进入纽约一所医院一星期后死亡。康涅狄格州流行病副总监素莎表示,她现在视耳念珠菌是大威胁的抗药性病菌,因为这种病菌很难消灭及被发现。
女童从26楼坠下 落地后奇迹发生!
从26层高楼坠下,生还的几率有多大?4月2日,奇迹降临在了一6岁女童身上。
4月2日下午1点10分,在重庆南川某社区,一名身穿红色衣服的小女孩不慎从26楼坠下。监控视频显示,女孩从高楼坠下后重重地撞在了彩钢棚上,彩钢棚被当场撞出一个大窟窿,部分材料掉下来一大片,地面一片狼藉。
“真的是太吓人了,我们看到心都揪起来了。”知情人称,女孩摔到彩钢棚后几秒钟,自己撑开压着的彩钢棚,爬了起来,并且还一个人独自步行离开了事发现场。《北京晚报》报道称,事发后,热心民众和家属将其送往医院。物业称, 疑似家属乘女孩熟睡将其反锁在家,女孩醒后打不开门从26楼坠落,幸好有彩钢棚接住, 仅右手骨折。“不幸中的万幸,还好有彩钢棚接住了,仅右手骨折。挽回了一条命。”物业工作人员说道。
目前, 这位女童正在医院进行治疗。
网友都在评论区感叹这孩子真是幸运,但这也提醒众多家长:任何时候都不要把小孩子独自一人放在家中,以防意外发生。
碧桂园要转型?开拓智能机器人
面对日趋饱和的房地产市场,中国销售额排名前列的房地产公司碧桂园开始向智能机器人行业转型,并将其定位为未来公司发展的主要业务之一。
“我们现在做的主要是两件事,一个是建筑机器人;一个是机器人餐厅。”碧桂园集团董事会主席杨国强说:“我希望未来5到10年,有相当一部分工作能由机器人来完成。” 碧桂园转型发展与行业规模见顶有关。近年来中国龙头房企万科、恒大均在探索转型发展,碧桂园则将航道瞄向了现代农业和机器人。
新成立的博智林机器人公司承载了杨国强的转型梦想。按照规划,未来5年碧桂园将在机器人领域投入至少800亿元人民币,尤其是建筑机器人。业内人士认为碧桂园发力建筑机器人领域,一方面可以借力在建筑领域的技术优势;另一方面也是接入其自身已有的应用场景,有利于产品的落地。
超跑4年还没运到中国 两中间人须赔逾30万元
一个华裔青年2015年毕业于卑诗大学(UBC),获母亲送赠一辆价值183,780加元的超级跑车,庆祝大学毕业,可是所有费用都支付后,仍未能在北京收到车辆,于是入禀卑诗最高法院追讨损失。法院日前裁定,两个中间人及所属公司须赔款超过30万元。 青年李大北(Da Bei Li,译音)计划在全部课堂完成后,立即返回北京,所以他迅速安排把母亲送赠的宝马(BMW)i8新车运到中国,他为此需要另外花运输费145,289元。
案情透露,原告在2015年2月23日与一个洋名哈里(Harry)的朴姓(Piao,译音)男子达成协议,后者在列治文经营一家车行。根据协议,朴哈里同意把原告的超级跑车运往中国及清关。 由于朴哈里没有足够的相关专业知识,因此他转而向经营一间公司的商人王群(Qun Wang,译音)寻求协助。 汽车到达天津 声称需14万清关 王群同意协助该部汽车清关,费用约为42,546元。王群坚持,当汽车到达天津港时,由自己的堂兄弟,而不是李大北的母亲,担任合法接收人。
这个变化意味着,王群和其堂兄弟在该部汽车抵达天津后,完全控制该车。 根据王群于2015年7月22日在短信中向朴哈里所称,从法律上而言,该辆汽车现归入他名字下。王群又称,需要另外14万元,汽车才能通过海关。不过,朴哈里表示,没有这么多钱。朴哈里要求王群归还汽车,连同自己已付的金钱。王群拒绝,表示除非朴哈里解决一宗完全不相关的商业纠纷,否则他不会归还该车。 同年10月,原告依然没有关于该车下落的消息,于是入禀法院,提出诉讼,控告朴哈里及其公司。后来,王群、他的堂兄弟及其相关公司被列为第三方。 卑诗最高法院法官贝克(Wendy Baker),在4月3日作出裁决,指原告支付了所有付运和清关费用,但是自从2015年3月委托朴哈里付运之后,便一直无见过该车。 贝克称,在审讯时,法庭仍没有收到该车下落的直接证据,只有王群的传闻证据,指该车在天津的仓库内。
贝克认为,王群并非一个可靠的证人,所以不接纳王群的传闻证据。 贝克裁定,朴哈里及其公司要共同承担原告委托把该车运往中国而支付的款项。另外,朴哈里、其公司及王群要为该车的价值负责。欠款总额为338,069元。还有,贝克表示,王群必须偿还原告所支付的清关费用。
三周只喝水减肥 妇女脑受损!
想要减肥,应该听从专家指示规律运动、健康饮食,否则伤了身体可就得不偿失了!以色列一名妇女听信“另类疗法治疗师”的偏方,3周内只喝果汁和水来减肥,最终导致水中毒(低钠血症),脑部很可能永久受损。
以色列特拉维夫一名40岁妇女,听从一名“另类疗法治疗师”的建议,连续3周只喝果汁和水减肥。《自由时报》报道,体重虽然成功降到到90磅以下(约40.8公斤),但身体也出状况,造成低钠血症。这名妇女目前正住院观察,但根据医生说法,女子的大脑已经受到损伤,而且很有可能永远无法复原。据悉,钠是人体内很重要的电解质,可以维持人体水分平衡,帮助神经肌肉运作。正常情况下,人体会自动调控水及钠的平衡,使血液里的钠离子浓度维持平衡。
但如果体内“水太多、钠太少”,钠离子浓度低于正常范围,就会引发低钠血症,严重可能出现休克、脑损伤,甚至死亡。
对冲基金远离股市 创七年来最差战绩
美股持续上涨,标普五百指数上周累计涨幅超过2%。远离股市的对冲基金,相对表现也越来越差。
根据Hedge Fund Research的报告,2019年的前三个月里,对冲基金表现相比上年大幅反弹,实现了4.9%的平均涨幅。华尔街见闻报道,今年1至3月,7种对冲策略都录得上涨,其中股票对冲和事件驱动型基金表现居前。只不过,比起标普13%的累计涨幅,对冲基金的表现实在难以差强人意。即使是表现最好的股票对冲基金,年初以来的获利也仅有6%,对冲基金行业今年创下了2012年以来最糟的开年表现。
而对冲基金也相当顽固。彭博援引摩根大通编制的客户数据称,尽管全球股市在过去三个月里市值增长了10万亿美元,对冲基金仍对股市敬而远之,3月底,对冲基金的看涨/看跌比率降至近一年新低。
去年下半年,对冲基金也和今天一样,谨慎地对股市保持观望态度。于是在标普五百大跌至熊市边缘时,对冲基金虽然没有完全置身事外,但他们的表现要好于大市。但是年初正是美联储转向鸽派,大量资金重回股市的时候。但对冲基金似乎认为,目前的美股反弹更多地由情绪驱动,Touchstone Advisors全球市场策略师Crit Thomas认为,如果基本面出现更加显见的转变,或许能让对冲基金回归股市。
有趣的是,对于对冲基金逊于大市的表现,投资者却没有用脚投票,离开他们。彭博援引摩根大通的另一项调查,约有三分之一的受访投资者表示,计划增加在对冲基金方面的资金配置,这一比例要高于2018年的15%。“至少表面上看来,这意味着越来越多的投资者认为市场是错的,怀疑者是对的。”
对冲基金还在加码押空。高盛指出,在3月的最后一周里,对冲基金继续卖出股票,并加大看跌押注,尤其是对金融股和工业股。对冲基金的净杠杆率进一步下滑2.2个百分点,至61.7%:他们毫无“动物精神”。
既然对冲基金不是股票的购买主力,那么谁是?美银给出了答案,一个熟悉的答案——企业回购。截至3月底,上市公司的回购规模已经达到了创纪录的2700亿美元。“对冲基金一开始错过了上涨,或许很多人认为,现在想再踏入市场已经为时过晚。”摩根大通分析师Marko Kolanovic称。
涉5年前打死华裔妇女 7旬男子受审拒认罪
5年前涉嫌袭击致华裔女子刘先竹死亡的男子陈寿权(Shoun Quan Chen,译音),被控二级谋杀案上周一开庭。陈寿权拒绝认罪。审讯预计须历时4周。
本报曾报道,陈寿权在2014年过堂时,其妻透露与丈夫10多年前从台山移民加国,曾在一食品厂工作,当时已退休。法庭文件显示,陈寿权生于1944年2月26日,被控告二级谋杀65岁女子刘先竹(Xian Zu Liu,译音)罪名。
事发在2014年10月15日。据《多伦多星报》报道,当天在多伦多市西Wallace-Emerson社区中心附近,保安录像拍摄到65岁的华裔女子刘先竹,清晨出门去晨运时,在路上遇到一个骑自行车的男子陈寿权,两人停下来交谈了约8分钟。
死者儿子认出疑凶
检控官Karen Simone对陪审团说,陈寿权突然动手殴打刘,并把刘先竹抛跌在地,“这个男人没有停止攻击,而是返回他的自行车,拿来一枝金属管,再次殴打该女子。”现年75岁的陈寿权,否认对他的二级谋杀控罪。
检控官又指出,当时陈寿权穿着特别的跑鞋和亮橙色的背心,在停止打人后,任由刘先竹躺在地上,先是到附近的草地藏好金属管,然后推著自行车,把自行车靠在社区中心近Dufferin和Dupont St的墙边,后来逃之夭夭。
一些路过市民见到刘先竹受伤,试图帮助她,但未能救回她的性命。她当天因钝性创伤致死。后来警方把监控录像录下的骑自行车男子照片,给刘先竹的儿子梅万朋(Wan Peng Mei)看,他认出疑凶是陈寿权,陈是他们家的朋友,曾是同一工厂的同事。
疑犯与死者一家曾是同事
Simone对陪审团说,金属管以及陈寿权的衣服鞋子和自行车上染有的血迹,都不能排除来自受害人。但Simone不清楚刘先竹为何被杀,但就肯定多项证据都可指证陈寿权。
上周一,刘的48岁儿子梅万朋作证。他说,他和父母以及陈寿权在一家工厂同事约十年之久,他在下班之后经常载陈回家,因此一眼即认出监控录像中的骑自行车男子是陈寿权。当陈的律师盘问,称梅同意图片中人并无特别特征时,梅通过广府话传译说,他很有信心能认出陈,“我知道这个人已十多年了!”
律师又问是否知道陈当时的精神状态,梅回答说不知道,但就据其母亲死前所说,陈的健康非常好。
把房龄少报了30年 加国地产经纪被罚惨了!
温哥华一个房地产经纪为客人卖屋时,把该间本身是1976年建造的房屋,错报为2006年兴建,犯了专业失当行为,现受到卑诗地产议会的4项处分,包括遣责、罚款5,000元及1,500元执法行政费。 卑诗地产议会称,黄锡学(Steven Siong Hok Oei,译音)自1995年担任持牌地产代理。
在2016年1月29日,他负责为一位业主,出售一幢位于本拿比瓦利街(Varley St.)的房屋。根据卖家与他任职地产的公司签署的挂牌合约,该物业开价1,888,888元。该间两层独立屋,最初建于1976年。业主在2005年开始对该间房屋大翻新,工程在2006年完成。 黄锡学预备好一份单张,列出该间房屋的基本资料,包括屋龄、室内面积和土地面积。在该张单内的大约兴建年份一栏内,填写了2006年,而非实际建造年份1976年,换言之该间房屋在2016年放盘时,屋龄实际上是40年,而非单张所填写的10年。 在2016年2月6日,该间房屋举行“开放日”,一个买家在其地产经纪的陪同下“睇屋”,当时黄锡学仍称该间房屋楼龄10年。 买家收估价单才发现 两天后,卖家与该买家达成买卖合约,购买价2,040,000元,并且无落条款。
同年3月8日,交易完成。 不过在2017年3月,买家接到卑诗物业估价署2017年估价单,指该间房屋的估值为1,837,000元,较购买价少了20.3万元,这引起新屋主的疑问,为何一间屋龄只有10年的房屋,估价会下跌这么多。向本拿比市政府询间后,新屋主才知道该物业实际上在1976年建造。 2017年5月8日,新屋主向卑诗地产议会投诉。经过纪律聆讯,卑诗地产议会纪律委员会在今年1月底裁定,黄锡学在此事上专业失当,认为黄锡学作为卖家的地产经纪,应该知道该间房屋原建于1976年。 纪律委员会对黄锡学作出4项处分,分别是予以谴责;要在90天内缴付5,000元罚款;要在卑诗地产议会指定的时间之内,自费完成“地产交易服务纠正教育课程”(Real Estate Trading Services Remedial Education Courses);以及在60天之内,向卑诗地产议会支付1,500元执法行政费用。
列治文山枪击案 嫌犯开着路虎跑了!
约克区警队第二分局刑事调查组,正就上周二烈治文山发生的枪击案展开调查工作,并呼吁公众提供有关线索,希望尽快拘捕涉案疑犯。
警方表示,枪击案发生于上周二晚上7时30分,警方接报后前往烈治文山的丽晶街(Regent Street)。
当抵达案件现场时,警员发现34岁受害人在其汽车内中枪受伤,送往医院抢救后,幸无生命危险。
涉事疑犯相信是驾驶黑色路虎(Range Rover)汽车逃去无踪,警方在Elgin Mills Road位于巴佛斯街及央街(Bathurst Street/Yonge Street)封锁数小时,其后重新开放。
任何人士目击上述案件发生过程,请向警方提供线索。
另外,负责调查的警员寻求在案发地点附近的商户或民居,能够提供闭路电视片段,或驾驶人士曾路经该处车前录像镜头可能拍下事件,可以协助警方追查疑犯的下落。
知情者请联络第二分局刑事调查组:1-866-876-5423,内线7241,或灭罪热线:1-800-222-8477,或在网上匿名提供资料,网址:www.1800222tips.com。
藏三文鱼箱腥味掩饰 60万元加国大麻越洋走私!
香港毒品调查科根据情报分析及深入调查后,昨日进行反毒品行动,下午在九龙红磡鹤翔街一个停车场内,破获一宗由加拿大空运到港的三文鱼藏大麻案,当场在8箱三文鱼的底部,总共发现32包重达8公斤的大麻,市值350万港元(约60万加元),拘捕2名正在拆货的男子,他们暂被落案控以一项贩毒罪。
消据香港毒品调查科行动组高级督察黄宝玲指出,被捕两名男子分别是35岁姓梁男子和29岁姓谢29岁男子,姓梁男子是一间海产公司的东主,谢男则报称无业,有黑帮和胜和背景。上月中,亦曾发生一宗类似由加拿大贩运大麻到香港案件(详另文)。 8公斤大麻藏于货箱底部 警方表示,被捕两人的贩毒行动相信已经运作数个月,据称,梁利用自己公司运三文鱼贩毒,试图用鱼腥味覆蓋大麻气味,将大麻由加拿大空运到香港,毒品相信用作供应香港当地市场。警方将继续调查,不排除会有更多人被捕,但未有透露该批大麻是寄自哪个加国城市。
黄宝玲透露,香港警方毒品调查科探员昨天中午时分,掩至红磡鹤翔街一个停车场埋伏,至下午3时许,姓梁及姓谢目标男子出现,2人在一辆轻型货车内,取出8个自加拿大空运抵港盛载三文鱼的货箱,以及2个红白蓝胶袋,2人就地拆货,当拆至第3箱时,探员冲出将2人包围截查,并搜查其余5箱货,在每箱底部发现有4包怀疑大麻,而两个红白蓝胶袋内亦藏有多包大麻,合共检获32包约重8公斤的怀疑大麻,毒品市值约350万港元。 梁及谢涉嫌“贩运危险药物”被捕,案件将于今日(6日)在西九龙裁判法院提堂。 香港警方重申,大麻于香港属危险药物,受《危险药物条例》134章规管,任何人士贩运、进出口均属刑事罪行,一经定罪,最高刑罚可处终身监禁及罚款500万港元。
洪堡冰球队惨烈车祸幸存者 多已重返球场
2018年4月6日,沙省发生一起惨烈车祸。巴士上共有16名球员和职员丧生,另有13人受伤。现在一年过去了。这13名幸存者有的已经重返冰球场,有的再也不能行走。但有一点他们是相同的:这13名年轻人为恢复到今天的程度,都付出了巨大的努力。
Morgan Gobeil,这名出生在洪堡的后卫在车祸中严重受伤。直到2019年3月4日才出院。他脑部受重创,不能说话,也不能行走。
他在医院里住了333天。这期间,他高中毕业,他的哥哥结婚,他度过了19岁生日。
Derek Patter在车祸中遭受硬膜下脑出血,胫骨和腓骨骨折。车祸后仅两个月,这名爱民顿出生的球员就发布视频,告诉人们他已 经重返冰球场。Patter的腿部仍有问题,他还要接受更多的康复治疗。
Brayden Camrud在车祸中受到严重脑震荡,一只胳膊和颈部失去知觉。他认为自己能活着,非常幸运。他在9月时说,“我得说我已经接近百分百康复了。”
这名沙省球员已经重返洪堡队参加比赛。他在常规赛中得55分,季后赛中得12分。
Xavier LaBelle这名沙省出生的后卫遭受16处脊椎骨折,脑部重创,脸部严重撕裂。19岁的Xavier能够行走,但仍需要治疗。他对车祸没有记忆。9月,他被Saskatoon Blades聘为冰球运营助理。他同时是the Saskatoon Contacts midget AAA的助理教练。
Tyler Smith在车祸中颈骨肩胛肋骨骨折,并发生中风。2018年11月,他下定决心重返洪堡队。他在打了10场比赛后,决定回到亚省Leduc的家中继续进行康复治疗。
Kaleb Dahlgren在4车祸中头骨骨折,头部有穿刺伤,脑部受伤,颈部和背部六处脊椎骨折。他的康复过程十分漫长。去年夏天,他追随去世教练Mark Cross的脚步,接受聘约在约克大学打冰球。
Bryce Fiske在车祸中颌骨裂成四块。他同时还发生颈部,颅骨,骨盆,和左肩骨折。
他来自沙省La Ronge。他于去年6月搬到了多伦多。他目前在安大略大学理工学院学习商业,并在Ridgebacks队打冰球。
来自温尼辟的Matthieu Gomercic在车祸中受到脑震荡,肩部脱臼,受到无数处撕裂伤。是最早出院的球员之一。和Fiske一样,Gomercic也进入了安大略大学理工学院,就读人体运动学,并在Ridgebacks队打冰球。
车祸发生前几秒钟,Nick Shumlanski的父母看着巴士经过他们家的农场。这名背部骨折和耳后骨折的前锋在车祸废墟中找到手机,给父母打了电话。和队友一样,这名来自沙省Tisdale的球员现在也在大学打冰球。他进入了爱德华王子岛大学Panthers冰球队。
Graysen Cameron这名来自亚省Olds的球员在车祸中背部骨折,眼骨骨折,并受到脑震荡。他去年6月重返冰球场,在the Red Deer Optimist Chiefs担任助理教练。
去年9月,他领养了一条服务犬,来帮助他面对车祸后的情感困扰。
Layne Matechuk这名后卫在车祸中严重脑部受伤,颅骨严重骨折,双肺破裂。他昏迷了一个月,醒来后又在医院住了5个月。他现在已经能够行走,但严重跛足。他仍在努力练习恢复说话。
Ryan...
一年了,民众伤痛挥不去…
周六是沙省洪堡野马青少年冰球队(Humboldt Broncos)惨剧发生一周年。洪堡球场
(Humboldt arena)在周六举行悼念仪式,在意外发生的下午4时50分,全场默哀。去年今日,一辆货车没有在停车指示牌前停车,撞向一辆巴士,导致巴士内16人死亡,13人受伤。当时巴士正载着野马青少年冰球队队员,前往比赛场地。
车祸震惊全国,并使整个洪堡社区陷入哀伤。有人发起筹款活动,筹到超过1,500万元善款,捐款者来自全球超过80个国家。
在车祸现场,有许多民众穿上冰球球衣,为死难者献花及祷告。举行悼念仪式的洪堡球场,在主要入口处张挂一排排黄色横幅,写上当时在巴士内的所有29人名字。
沙省省长与妻子一同出席
沙省省长斯科特莫(Scott Moe)与妻子一同出席悼念仪式。
总理杜鲁多在周六发表声明,赞扬最先抵达现场的紧急服务人员,称他们在如此严重的车祸中,依然表现出专业精神和勇气。杜鲁多并赞扬洪堡市的居民,在车祸后所展现的坚强和恢复能力。
肇事货车司机西度(Jaskirat Singh Sidhu),较早前被判不小心驾驶导致他人死亡及受伤罪成,被判入狱8年。西度是一名新手货车司机,他当天是第一次驾车经过车祸路段。自从惨剧发生后,已有3个省份规定商业货车司机,必须进行强制性训练。此外,一套全国性的基本训练标准,将于明年推出。
中国舞蹈学会民族舞团招生啦!了解一下
中国舞蹈学会民族舞蹈团,以推广中国民族舞蹈艺术为宗旨,并且经常参与各类型演出。
现招收儿童、青少年及成人学员,逢星期五晚上及星期六下午于烈治文山市上课。
欢迎电邮至cdwfdg@hotmail.com或致电289-637-9898查询。
网址:www.chinesedanceworkshop.org。